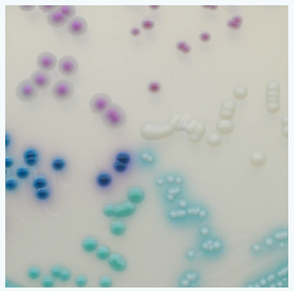
"Differentiation of Candida species on CHROMagarTM  Candida Chromogenic agar. C. auris colonies are  light blue with a blue halo. Image Source: CHROMagarTM"

Submitting AR Specimens to DSHS Lab
How to Use This Submission Guide
The steps to submitting specimens to the Texas AR Laboratory are outlined in the graphic below. Clinical specimens or isolates that meet the criteria identified in the Submission Criteria table below should be submitted.
Select a step from the list below to go to more detailed guidance for each type of clinical specimen or isolate.
- (New Users Only) Request a Submitter ID
- Obtain a Specimen Submission Form
- Collect and Label Specimen
- Ship Specimen to Texas AR Lab
If you have questions about this submission guide, email TexasARLN@dshs.texas.gov.
AR Specimen Submission Criteria
Clinical specimens and isolates that meet the criteria identified in the table below should be submitted to DSHS for further testing.
Recommendation | CRPA | CRE | CRAB | Neisseria gonorrhoeae (GC) | Candida spp |
---|---|---|---|---|---|
Recommended Clinical Specimen Types | Rectal swab | Rectal swab | Rectal swab | Vaginal swab Endocervical swab Urethral swab Oral swab Rectal swab Nasopharyngeal swab Penile Meatal swab Conjunctival swab (neonates) | Rectal swab Axillary swab* Groin swab* Nares swab Oropharynx swab External ear swab Vaginal swab (*Axilla and groin should be swabbed together using one swab) |
Recommended Isolates | P. aeruginosa resistant to at least one imipenem, meropenem, or doripenem AND Nonsusceptible (intermediate or resistant) to cefepime or ceftazidime | Escherichia coli, Klebsiella oxytoca, K. pneumoniae and Enterobacter spp. resistant to any imipenem, meropenem, doripenem, or ertapenem. Providenicia, Proteus, Morganella, Citrobacter and Serratia resistant to any meropenem, doripenem, or ertapenem. | Acinetobacter baumanii resistant to imipenem, meropenem, or doripenem | At least one viable colony of N. gonorrhoeae isolate | At least one viable colony of C. auris. |
CLSI breakpoints: (Minimum Inhibitory Concentrations in µg/mL | Imipenem ≥8 Meropenem ≥8 Doripenem ≥8 Cefepime ≥16 Ceftazdime ≥16 | Imipenem ≥4 Meropenem ≥4 Doripenem ≥4 Ertapenam ≥2 | Imipenem ≥8 Meropenem ≥8 Doripenem ≥8 | Azithromycin >1 NS Cefixime >0.25 NS Ceftriaxone >0.25 NS Ciprofloxacin ≥1 R NS= Nonsusceptible R=Resistant OR In the absence of AST, any GC in which treatment failure rather than reinfection is suspected. | N/A |
Transport Media for Isolates | Any non-inhibitory, non-selective agar plate or slant (e.g. Sheep Blood Agar, Tryptic Soy Agar, etc.), or broth | Chocolate agar slants | Sabouraud’s Dextrose Agar slant or other appropriate media. CHROMagarTM Candida plates, if available, are best for isolation. | ||
Lab Test Offered |
| Ceftriaxone susceptibility (ETest); Ciprofloxacin susceptibility; MALDI-TOF mass spectrometry; Beta lactamase detection. Azithromycin and Cefixime susceptibility (for research use only) | MALDI-TOF mass spectrometry |
Specimen Submission Steps
1. Request a DSHS Lab Submitter ID (Facilities with a current Submitter ID, skip this step)
NEW USERS and users updating any information previously submitted, please complete every applicable field of a Submitter ID Request Form and email the completed form to labinfo@dshs.texas.gov, or fax it to (512) 776-7533.
2. Obtain a Specimen Submission Form
Once you have a Submitter ID, request a master copy of the required specimen submission form from Laboratory Reporting by emailing LabInfo@dshs.texas.gov or calling (512) 776-7578.
A submission form is required for each specimen.
Please refer to the table below to identify the correct submission form for each organism type.
Organism: Clinical Specimen or Isolate | Required Submission Form | Special Instructions | |
---|---|---|---|
For Clinical Specimen | For Isolate | ||
CRE (Escherichia coli, Klebsiella oxytoca, K. pneumoniae and/or Enterobacter spp.) | G-2E | Check off “Colonization Testing Only” in Box 2 and write “CRE” in space provided. | Check off “CRE: Carbapenem Resistant Enterobacterales” in Box 1 of Section 4 |
CRAB | G-2E | Check off “Colonization Testing Only” in Box 2 and write “CRAB” in space provided. | Check off “CRAB: Carbapenem Resistant Acinetobacter” in Box 1 of Section 4 |
CRPA | G-2E | Check off “Colonization Testing Only” in Box 2 and write “CRPA” in space provided. | Check off “CRPA: Carbapenem Resistant Pseudomonas Aeruginosa” in Box 1 of Section 4 |
Candida spp. | G-2E | Check off “Colonization Testing Only” in Box 2 and write “Candida auris” in space provided. | Check off “Candida identification by MALDI (Candida susceptibility may be performed) in Box 1 of Section 4 |
Suspected treatment resistant Neisseria gonorrhoeaea | G-2B | In Section 5, under “Definitive Identification” column, mark “Neisseria” and under “Clinical specimen” column, write “GC AST Test”. Leave Section 9 empty. | In Section 5, under “Definitive Identification” column, mark “Neisseria” and write “GC AST Test” next to it. Leave Section 9 empty. |
It is vital that specimens are collected, labeled, and submitted correctly. Failure to submit a specimen as required will result in DSHS’ refusal to perform the requested services. (Tex. Admin. Code §73.31). Collection guidance Refer to the Laboratory Testing Services Manual for test-specific submission requirements.
Specimen Labeling Requirements
The following specimen labeling/submission requirements must be met otherwise the specimen will not be tested.
- Every specimen must have at least two unique patient identifiers affixed to it.
- Every specimen must have an accompanying submission form.
- Patient-specific identifiers on the specimen and the submission form must match exactly.
Acceptable specimen identifiers include but are not limited to
- Patient’s Name
- Patient’s Date of Birth
- Patient’s Medical Record Number
- Specimen ID Number
- CDC Number
- Unique Random Number
- Medicaid Number
- Date of Collection
Note: Location-based identifiers such as hospital room number or street address are NOT acceptable.
Three patient identifiers are provided on this label
1. patient’s name,
2. date of birth, and
3. specimen ID number.
A minimum of two is required.
Providing a completed submission form with each specimen is critical to successful testing. The unique patient identifiers on the specimen must exactly match the identifiers on the submission form. Missing information and/or mismatches between patient identifiers on specimens and submission forms will result in specimens not being tested, causing delays in patient treatment and potentially unnecessary morbidity and mortality.
All three patient identifiers on specimen label match submission form exactly.
Patient’s name on specimen label is shortened and ID number provided does not match submission form. Only one patient identifier on label and form match, so the specimen is unsatisfactory for testing.
AR Laboratory Specimen Submission Guidance by Organism
Use the table of contents below for quick links to AR organism-specific submission guidance.
• CRO Specimen Submission Criteria
• CRO Specimen Submission Steps
• CRO Specimen Collection Instructions
• CRO Specimen Labeling Requirements
• CRO Specimen Submission Form (G-2E) Instructions
• Candida Specimen Submission Criteria
• Candida Specimen Submission Steps
• Candida Specimen Collection Instructions
• Candida Specimen Labeling Requirements
• Candida Submission Form (G-2E) Instructions
• AR GC Submission Criteria
• AR GC Specimen Submission Steps
• AR GC Specimen Collection Instructions
• AR GC Specimen Labeling Requirements
• AR GC Specimen Submission Form (G-2B) Instructions
CRO Clinical Specimen Swab Collection
Before collecting CRO specimens, permission must be obtained from a DSHS healthcare-associated infections (HAI) epidemiologist. Please email the HAI epidemiology team at ICAR@dshs.texas.gov. The Laboratory will provide swabs, mailing boxes, and UN3373 labels to CRO submitters upon request from an HAI epidemiologist.
The HAI epidemiologist can help coordinate with shipping specimens to the Laboratory.
Only CRO rectal swab specimens collected using rayon-tipped, plastic applicator Copan Cepheid dual swab collection devices can be accepted for testing. Specimens collected with other swab kits will not be tested.
- Use Copan Cepheid Sterile Transport Dual Swab collection and transport kits (Cepheid Catalog # 900-0370) for specimen collection.
- Make sure the collection kit being used is not expired!
- Swabs may be stored at ambient temperatures before shipping.
- Ship CRO swabs within one day of collection as testing must begin within five days of collection.
Detailed guidance on specimen collection protocol for CRE, CRAB, CRPA (CROs) may be found

Appropriate Transport Media for CRO Isolates
- Submit CRO isolates on a non-inhibitory, non-selective agar plate or slant (e.g., sheep blood agar, tryptic soy agar).
- A pure, low-passage CRPA isolate is preferred as some carbapenem resistance mechanisms are plasmid-based and can be lost following multiple subcultures.
Candida spp. Clinical Specimen Swab Collection
Use nylon flocked Copan ESwabTM collection and transportation kit to collect specimen for C. auris colonization testing. Swabbing the skin of the groin and axilla (armpits) reportedly yields the highest concentration of C. auris. The preferred collection method is for the groin and axilla to be swabbed with the same swab. Other areas that may be swabbed include nares, oropharynx, external ear canal, vagina, and rectum.
Please DO NOT USE Copan Transystem swabs, which are designed for CRO Colonization testing.
Check to make sure the lid of each ESwab is firmly closed and appropriately labeled.
Make sure the collection kit is not expired!
PLEASE NOTE:
- Permission must be obtained from a DSHS healthcare-associated infections (HAI) epidemiologist before collecting and submitting Candida surveillance specimens to the Laboratory.
- Please email the HAI epidemiology team at ICAR@dshs.texas.gov to obtain permission.
- The HAI epidemiologist can help provide swab collection kits and coordinate with shipping specimens to the Laboratory.


ESwabTM Collection Kit for Candida specimens. Copan Regular Size Nylon flocked swab with liquid Amies may also be used for specimen collection. Photo Source: DSHS (2022)
*If an ESwab specimen container is accidentally spilled, please recollect the sample with a new ESwab. Do not add liquid into the ESwab tube or attempt to retrieve spilled liquid.
- Ship Candida swabs within 1 day of collection.
View detailed CDC instructions for collection of patient swabs for C auris testing.
Appropriate Transport Media for Candida Isolates
- Submit isolates on Sabouraud’s Dextrose Agar (SDA) slants or other appropriate media.
- CHROMagarTM Candida Chromogenic agar (if available) is the most appropriate medium for isolating colonies. Isolates may be submitted on CHROMagarTM Candida Chromogenic agar.
- Multiple commercial companies sell CHROMagarTM Candida media and at least one company sells powder for making the media in-house.
The AR Laboratory will provide SDA slants to submitters upon request. Call the AR lab at (512) 776 – 7342 to request slants.
Permission from an HAI epidemiologist is not needed prior to submission of isolates. The Laboratory does not supply CHROMagarTM Candida Chromogenic agar slants to submitters.
- Multiple commercial companies sell CHROMagarTM Candida media and at least one company sells powder for making the media in-house.
The AR Laboratory will provide SDA slants to submitters upon request. Call the AR lab at (512) 776 – 7342 to request slants.
Permission from an HAI epidemiologist is not needed prior to submission of isolates. The Laboratory does not supply CHROMagarTM Candida Chromogenic agar slants to submitters.
Candida Chromogenic agar. C. auris colonies are
light blue with a blue halo. Image Source: CHROMagar™

Image Source: Hardy Diagnostics
Neisseria gonorrhoeae (GC) Clinical Specimen Swab Collection
Neisseria gonorrhoeae is fastidious and requires special collection and handling for enhanced survival. Clinical specimens from patients with suspected gonorrhea treatment failure may be submitted using the Copan Liquid Amies Elution Swab (ESwab™) collection and transport system. Pure cultures may be submitted on Chocolate II Agar slants or other appropriate media. Specimen collection kits and mailing containers can be provided by DSHS. Specimens from the following swab sites may be submitted for GC susceptibility testing:
- Vaginal
- Endocervical
- Urethral
- Oral
- Rectal
- Nasopharyngeal
- Penile Meatal
- Conjunctival (neonates)
Copan Liquid Amies Elution Swab (ESwab™) collection kits are required for GC collection. Please note the swab size required will depend on the collection site. Refer to Obtaining AR Specimen Collection Kits and Mailing Containers from DSHS Laboratory for shipping details.
For penile, urethral, or conjunctival specimens: Use Copan ESwab™ Minitip Nylon flocked swab with liquid Amies (Copan Catalog # 481C).
Copan ESwab™ with flocked nylon mini tip and Amies liquid. Image Source: DSHS (2022)
For oral, nasopharyngeal, rectal, or vaginal specimens: Use Copan Eswab™ Regular Size Nylon flocked swab with liquid Amies Copan Catalog # 480C or Copan Transystem 108C with Amies gel with Amies gel.
Copan Eswab™ Regular Size Nylon flocked swab with liquid Amies Copan Catalog # 480C. Copan Transystem 108C with Amies gel may also be used for GC swab specimens. Image Source: DSHS (2022)
Please make sure the collection kit being used is not expired!
- Stocks of these swabs are available at no charge from the Texas AR Lab. Call (512) 776 - 7582 to request GC swab collection kits.
- GC specimen collection kits and mailing supplies may be ordered from the AR Texas Laboratory.
Further GC AST specimen collection guidance is found on the GC AST specimen collection guidance instructions page on the Laboratory Testing Service Manual, and AR GC test page.
Appropriate Transport Media for Neisseria gonorrhoeae (GC) Isolates
Neisseria gonorrhoeae isolates from patients with suspected gonorrhea treatment failure may be submitted on chocolate agar slants or other appropriate media. The AR Laboratory does not supply isolation media to submitters.
Chocolate Agar Slant
Image Source: Hardy Diagnostic
Required Fields on Specimen Submission Forms
If submitting specimens for carbapenem resistance testing or Candida spp. specimens, request Form G-2E. Neisseria gonorrhoeaea specimens require Form G-2B.
To improve legibility and minimize transcription mistakes, use only BLOCK CAPITAL LETTERING when filling out submission forms. Avoid using cursive script.
The following information is required on every submission form:
- Submitter or Ordering Physician’s Complete Contact Information
- Submitter or Ordering Physician’s Texas Provider Identifier (TPI) Numbers
- Patient’s Name, Date of Birth, and Physical Address
- Billing Information (if the patient is Medicare or Medicaid eligible, the appropriate Medicare or Medicaid number must be provided)
- Specimen Collection Date and Time
- Symptoms and Diagnosis Code(s) (provide only when required and available)
- Specimen Source
- Specimen Storage Temperature (provide when required)
- Type of Test Requested
- Collection Site Name (In Form G-2E Only)
The required fields in submission forms G-2E and G-2B are identified below.
Submission Forms Instructions
Sample G-2E Submission Form Showing Required Fields* (CRO and Candida sp. Specimens)
Sample G-2B Submission Form Showing Required Fields* (N. gonorrhoeae (GC)
- *The patient information/unique identifiers on the submission form MUST exactly match the patient information provided on the specimen. If they do not match, the specimen will be considered unsatisfactory (unsat) and will not be tested.
- All required fields are marked with double asterisks (**).
- Do not bundle a submission form with two or more specimens.
Questions about specimen submission forms can be directed to the Laboratory Reporting Group at 1-888-963-7111 ext. 7578 or email: LabInfo@dshs.texas.gov.
Required Fields on Submission Forms, Explained
Section | Required Fields |
---|---|
Submitter’s National Provider Identification (NPI) Number SECTION 1 | All health care providers must include their NPI number. To obtain an NPI number, contact the National Plan and Provider Enumeration System (NPPES) toll free at (800) 465-3203 or via their website at https://nppes.cms.hhs.gov/#/ |
Submitter’s Texas Provider Identifier (TPI) Number SECTION 1 | The TPI number is a unique number the DSHS Laboratory assigns to each of our submitters. To obtain a Texas Provider Identifier (TPI) number, contact Texas Medicaid and Healthcare Partnership (TMHP) at 1-800-925-9126. To request a DSHS submitter number, a master form, or to update submitter information, please call (888) 963-7111 ext. 7578 or (512) 776-7578, or fax (512) 776-7533. Alternatively, visit https://www.dshs.texas.gov/laboratory-services/laboratory-testing-services-manual-forms-laboratory-fee-schedule#email |
Submitting Facility’s Name and Address SECTION 1 | Provide the submitter’s name, address, City, State, and zip code. Clearly print, use a pre-printed label, or use a legible photocopy of a master form provided by the Laboratory Services Section. |
Submitting Facility’s Point of Contact Information SECTION 1 | Provide the name, telephone number, and fax number of the point of contact (POC) at the submitting facility in case the laboratory needs additional information about the specimen or isolate. |
Clinic Code SECTION 1 | Provide only when applicable. The clinic code identifies the satellite office that submitted the specimen to the submitter. It helps the submitter identify where the lab report belongs in situations when the submitter has a primary mailing address with satellite offices. |
Patient Information SECTION 2 | Complete ALL required fields in this section. The patient’s first and last name provided on the specimen MUST match the patient’s name on this form. All specimens MUST be labeled with at least two patient-specific identifiers; both a primary and a secondary identifier. The identifiers used MUST appear on both the specimen container and its submission form. Specimens that do not meet these identifier requirements will be classified as unsatisfactory for testing and will not be tested. |
Specimen Source or Type SECTION 3 | Indicate the type of material or the source of the specimen or isolate being submitted. For specimens not described in the list, check the “Other” option, provide specific details, and initial next to them. |
Ordering Physician’s Information SECTION 5 (Form G-2E) SECTION 6 (Form G-2B) | Provide the name of the physician who ordered the test and the physician’s NPI number. |
Payor Source SECTION 6 (Form G-2E) SECTION 7 (Form G-2B) | On Form G-2E, the payor is by default selected as a CDC Special Project. On Form G-2B, select “HIV/STD” for the GC AST test. |
Collection Site Information SECTION 7: (Form G-2E Only) Required | Provide the collection site name, infection control contact name, phone number, zip code and sample number. Include the collection site’s CLIA number, if applicable. |
Test Requested SECTION 4 (Form G-2E Only) | You MUST identify the specimen as either an isolate or a clinical specimen. Complete Box 1 for isolates. Complete Box 2 for clinical specimens submitted for colonization and identification. Do NOT fill out both Boxes. For isolates, you must check the specific test(s) to be performed. To cancel a test marked in error, place a single line through the test name and write “error”. For colonization testing (Box 2), provide the name of the suspected organism. Provide copies of any previous laboratory testing of this specimen/isolate to assist DSHS with the identification process. |
Test Requested (Bacteriology) SECTION 5 (Form G-2B Only) | Under “Definitive Identification” mark “Neisseria” and write “GC AST Test” in the space next to it. |